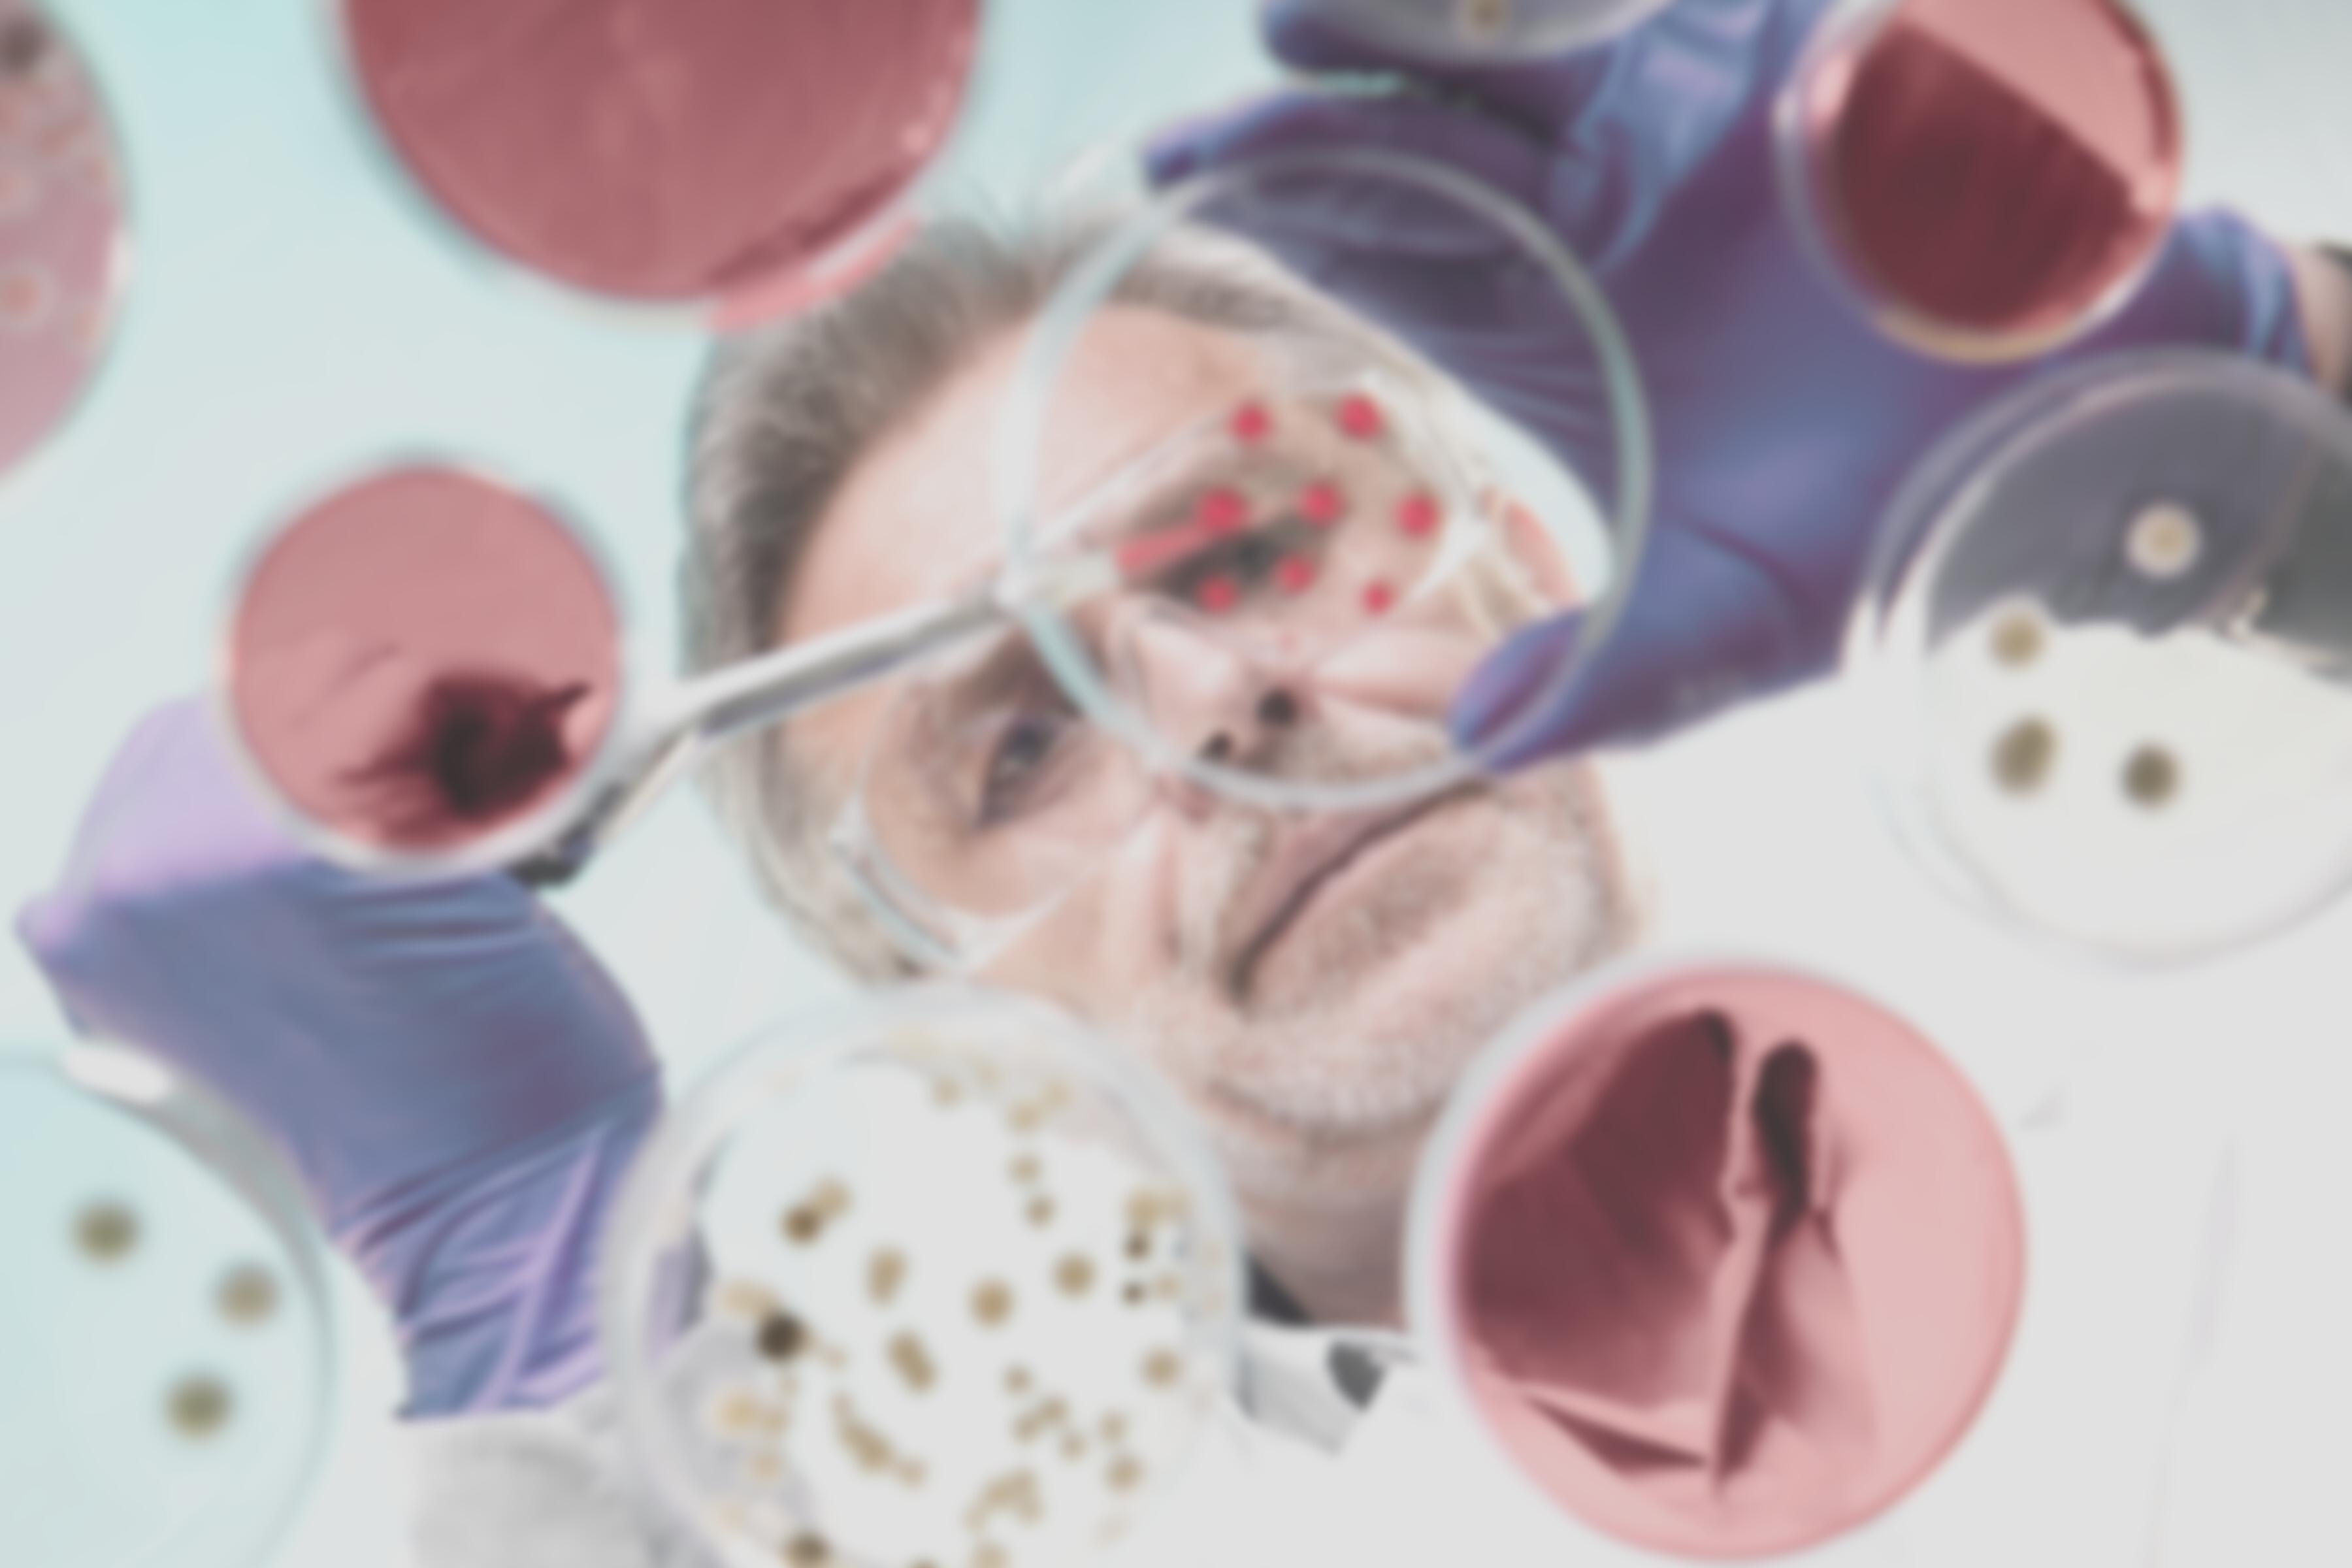

N o . 1 | J a n u a r y | 2 0 2 3
The Research Edition N e w s FROM THE FOUNDATION WORKING TO END MELANOMA
01 02 03 04
From the Desk of Alicia Rowell, Vice President AIM at Melanoma Foundation
Tissue is the Issue
2023 Update on AIM’s International Melanoma Tissue Bank Consortium

Notes from the Lab: T-Cell Engagers, the Next Stage in Cancer Immunotherapy?
By Paul Bunk, Ph D candidate, Cold Springs Harbor Laboratory
What Makes AIM’s International Melanoma Tissue Bank Consortium Even More Valuable
Articles
FROM THE
DESK OF A l i c i a R o w e l l
VICE PRESIDENT | AIM AT MELANOMA FOUNDATION

Happy new year to you and your families! I hope that 2023 has started well for you
Before I delve into a preview of this month’s newsletter, I want to thank our entire community for the generosity shown to AIM in 2022 and especially over the month of December Your support of our mission is appreciated, and I want to assure you that we use your funds wisely In fact, I am proud to announce that we just earned a FourStar Rating from Charity Navigator This rating designates AIM at Melanoma as an official “Give with Confidence” charity due to our strong financial health, ongoing accountability, and transparency It indicates that our organization is using its donations effectively based on Charity Navigator’s criteria This rating is in addition to our previous and current (2023) Platinum Seal of Transparency from Guidestar, indicating we have the highest level of transparency about our mission and financials
Our focus for this month’s newsletter is research and treatment
I want to direct you to a compilation of our 2022 In Plain English articles written by Dr Kim Margolin You can read the publication here These articles are one of the most read series of all we offer, and I understand why: Dr Margolin takes the most recent melanoma research and treatment news and delivers it to you in easily understandable language If you missed one or want to refer back to one, you can now easily access them
Check out the article in our series called “Notes from the Lab,” by guest author Paul Bunk Paul is a Ph D candidate at Cold Spring Harbor Laboratory studying immunotherapy and has given us an in-depth look at Bispecific T-Cell Engagers, including how and why they work in uveal melanoma For those of you who like to read about the science, this article is for you.
There is also an article about a very important aspect of the International Melanoma Tissue Bank Consortium (IMTBC): the Epidemiological Survey Patients who give their tumor tissue to IMTBC take this survey, and the answers (depersonalized) are a treasure trove for research Please read this article to understand more about how the tissue bank works and the type of research that can be performed with the survey ’ s information.
Related, I hope some of you were able to watch the webinar on Wednesday, January 25th, that featured Dr Mohammed Kashani-Sabet and me in a conversation about IMTBC If you didn’t see it, you can watch it anytime with this link.
We’ve also included a general update on the International Melanoma Tissue Bank Consortium (IMTBC), including an updated FAQ, based on an article we wrote last year We are excited by the progress and eager to see more in 2023
Thank you again for your support of AIM at Melanoma and all of our initiatives, especially IMTBC Enjoy this month’s newsletter!
Our focus for this month’s newsletter is research and treatment.
1
TISSUE ISTHE
Issue
2023 Update on AIM’s International Melanoma Tissue Bank Consortium



AIM at Melanoma’s major research initiative the International Melanoma Tissue Bank Consortium (IMTBC) is the first of its kind in the world Currently comprising four sites in the U S (with two Australian sites to be added), the IMTBC is a resource of primary melanoma tumor tissues and data for use by the participating institutions’ researchers as well as researchers around the world who can apply to use the tissue/data
As we noted last year, COVID hit research projects like this hard, as only “essential” medical appointments were scheduled during the pandemic And since then, offices and patients have been slowly getting back to normal As you’ll read below, the typical way we collect a primary tumor tissue is at one of four research institutions during a skin check appointment Since these institutions are also major hospitals, getting back to normal has been complicated because COVID affected hospitals in a much different way than it did independent physician offices But we are moving in the right direction, and collection resumed and continued at all four U S sites in 2022
As of the end of the 3rd quarter (September 30, 2022) reporting, we have collected 110 fresh frozen primary tissues and corresponding data
2
FAQS ABOUT THE TISSUE BANK

WHAT IS THE TISSUE BANK IS IT AN ACTUAL BUILDING?
The IMTBC is not a building It operates within certain existing medical centers Dermatologists, surgeons, oncologists, pathologists, and other staff all participate in creating the bank at a participating cancer center
HOW DOES IT WORK?
Here’s how it typically works: A patient goes to see his or her dermatologist for a skin check at one of the tissue bank locations The physician finds a lesion suspicious for melanoma and intends to biopsy it Before the excision begins, the physician asks for consent from the patient to use some of the tissue and the patient’s medical information depersonalized for research If granted, a portion of the tissue is removed for the biopsy, and a portion is frozen immediately, which, critically, preserves RNA The doctor also asks the patient to fill out a special questionnaire and collects other samples such as blood Staff enter the patient’s medical record and questionnaire answers (again, all depersonalized) into a special database, and the samples and tissue are coded and stored in refrigerators/freezers
The bank, then, is made up of both fresh frozen tumor tissue and other samples, such as blood, as well as data about each patient
WHAT WILL THE RESEARCHERS DO WITH THE TISSUE AND ACCOMPANYING PATIENT INFORMATION?
Once a critical mass of tissues and data are collected from a variety of patients, the researchers can look at these fresh frozen primary melanomas and the accompanying data to find medical signs or indications, called biomarkers, that are shared by some or all of the tissues These biomarkers will help reveal insights into diagnosis, prognosis, and treatment Please read this article for even more information
WHY IS IMTBC UNIQUE?
IMTBC is a global first because of the following combination of factors:
It’s a consortium the investigators at the institutions are sharing data and tissue samples with each other

It’s collaborative tissue samples and data will be available for researchers around the world to apply to study

The tissue is fresh frozen RNA is preserved, unlike in the standard formalin fixed, paraffin embedded process
The tumors are primary not metastasized
There will be a critical mass a goal of 500 to start, and continued collection thereafter
Full annotation will accompany each tissue patient data, including full medical history (depersonalized), will be available for study along with the tissue
Samples accompany each tissue blood and other samples are collected for each patient
3
CAN I PARTICIPATE?
This question is the most common one we get
At this time, only certain people can participate, and they likely won’t be anyone who is reading this article Why? Remember that we are collecting primary melanoma tumor tissue primary means the original melanoma found on your body, the one that was deemed Stage I or Stage II Those who are reading an article like this are probably long past that original biopsy though they may be able to participate if they have a second primary melanoma Further, the patient needs to be seen at one of our tissue bank sites at Hillman Cancer Center, University of Pittsburgh Medical Center (Pittsburgh, PA); Knight Cancer Institute, Oregon Health and Science University (Portland, OR); California Pacific Medical Center (San Francisco, CA); or Robert H Lurie Comprehensive Cancer Center, Northwestern University (Chicago, IL) Finally, the suspected melanoma must be large enough to bank
So ironically, it is people likely unfamiliar with the melanoma world and melanoma research because at the time of the biopsy, they won’t even know if they have melanoma whose information and samples will populate this bank and help researchers understand melanoma better
We hope in the future to have more U S sites so we can collect more primary tissue, but for now, we are limited to collecting at the above four U S locations
The highest degree of genetic alterations is found in the primary tumor During the course of the disease, the tumor loses large DNA fragments For research, you want to look at the tumor at several “time points,” if possible, starting most importantly with the primary tumor
If we are going to find predictive or prognostic markers, it will be in the primary tumor
By contrast, metastasized tumors are a product of the organ in which they are growing, and they will reflect that organ Some tumor cells go to the lymph nodes, and other cells go into the bloodstream, so you don’t get a full picture of the person’s disease from the metastases
If primary melanoma tissue that is fresh frozen is so important for research, why isn’t there more available?
One reason is that fresh frozen primary melanoma tissue cannot be collected and frozen in a typical dermatologist’s office, and a typical dermatologist’s office is where most melanoma biopsies take place Most dermatology offices do not have an in-house pathologist, and therefore the dermatologist must physically send their biopsies to an outside pathology office That situation eliminates the ability to safely separate a portion of the sample and flash freeze it for research without compromising the diagnosis, particularly if the melanoma is small Even when a dermatologist’s office has an in-house pathologist, most dermatology/pathology offices do not have the time, set-up, or all of the materials needed to quickly freeze the tissue (using liquid nitrogen) or store it (liquid nitrogen freezers operate at –140°C to –196°C) Part of the samples also need to be processed immediately, requiring an on-site laboratory, which is not available in a typical dermatology clinic And none of the above difficulties includes the very complicated procedures and rules around gathering consent of patients for tissue collection and using that tissue for research again, a typical dermatology office does not work in this realm
Formalin-fixed, paraffin imbedded is the standard way of storing primary tumors In this method, a lot of water is depleted from the tissue, which degrades the proteins
The messenger RNA is also degraded into smaller pieces during the fixing process, and researchers want the messenger RNA intact Fresh frozen tissue preserves RNA Finally, a tumor cell has already initiated an immune response, and researchers are able to recognize that in a fresh frozen piece but not in a formalin-fixed piece
Dermatology offices located at research institutions, however, with on-site pathology offices and on site laboratories and appropriate space and equipment, are the places that can successfully separate, freeze, and store fresh frozen primary tissue for research But even these places need to be organized, managed, and paid to consent patients appropriately; to put the collection processes in place; to label and store tissue; and to oversee the use of the tissue by internal and external researchers This organization, management, and funding are what IMTBC has successfully accomplished
WHAT HAPPENS NEXT?
WHY IS PRIMARY TUMOR TISSUE IMPORTANT?

The information in the primary tumor is important because it is fixed The heterogeneity of the disease can only be read in the primary tumor it’s the best place to understand the heterogeneity of the disease There is a tremendous amount of information in the primary tumor that can help us predict the future for the patient if we can learn to read it The primary tumor has ALL the information about the disease
Critical mass is important We are at 110 tissues, and the site researchers wanted 100 tissues at the very least to begin their research the more tissues, the more that can be revealed through their studies so this year, we should see the first research project(s) using the tissue
We are in initial conversation with another U S institution to join the consortium, and we are in continued conversation with our Australian sites on the “how” of collection, collaboration, and processes and hope that they can officially open soon We will announce any and all news as it happens!
 WHY IS FRESH FROZEN TISSUE IMPORTANT?
WHY IS FRESH FROZEN TISSUE IMPORTANT?
4
NOTES FROM THE LAB
T-Cell Engagers, the Next Stage in Cancer Immunotherapy?

 By Paul Bunk, Ph.D. candidate, Cold Springs Harbor Laboratory
By Paul Bunk, Ph.D. candidate, Cold Springs Harbor Laboratory
In January 2022, tebentafusp-tebn, also known under the more easily pronounceable brand name Kimmtrak, was approved for the treatment of unresectable or metastatic uveal melanoma. This treatment is the first and, so far, only FDA-approved therapy for this rare kind of cancer. Tebentafusp-tebn (“tebe”) is also an example of a growing new class of immunotherapies, called bispecific T-cell engagers, which includes the leukemia drug blinatumomab (Blincyto). But what are T-cell engagers, how do they work, and why have they now proven to be effective in metastatic uveal melanoma, a cancer that seems to be resistant to other currently available immunotherapies?
How T-cells recognize cancer
To understand T-cell engagers, we first have to look at the body’s adaptive immune system. The adaptive immune system is tasked with recognizing and eliminating anything that can harm the body, including pathogens such as bacteria and viruses, as well as tumors. Tcells are part of the adaptive immune system and are tasked with directly killing cancerous or infected cells.
The adaptive immune system generally distinguishes between self and foreign—in other words, it differentiates between healthy cells of the individual and cancerous cells, or infected cells that pose a threat. T-cells distinguish self and foreign by recognizing fragments of proteins—we call these peptides—that are being presented to T-cells by MHC (major histocompatibility complex) molecules on the surface of cells. These MHC molecules tightly control the recognition of damaged or mutated peptides from infected or malignant cells by T-cells. In the case of infections, identification and destruction of infected cells by T-cells results in a rapid and strong immune response, due to the presence of peptides in viruses that are very different from those of healthy human cells.
In the case of cancer, identification and destruction of the malignant cells is less efficient, because human cancers have a limited number of peptides that T-cells can recognize as foreign as well as often lack the MHC molecules required to present those peptides to the T-cells. Some tumors harbor a large number of mutations, often due to high levels of DNA damage or lack of enzymes that repair DNA.
This leads to a lot of cancer-reactive Tcells to enter the tumor and kill the tumor cells by recognizing its mutated peptides. This type of cancer is what we call immunologically ‘hot’
Other tumors have only a small number of mutations—what we refer to as a low mutational burden—and are called immunologically ‘cold’ due to the low number of T-cells in the tumor. This absence of T-cells is caused by the low mutational burden resulting in few mutated peptides that can be recognized by Tcells.
Besides the lack of immunogenic peptides in many tumors, T-cells often have to face other hurdles that limit their ability to enter the tumor and kill cancer cells. For example, even when a cancer has a high mutational burden and a lot of cancerreactive T-cells, these T-cells often lose their ability to properly attack cancer cells inside the tumor. This immune ‘dysfunction’ is caused by a number of mechanisms, one of which includes tumors prompting the immune system to put ‘brakes’ (often called ‘checkpoints’) on T-cells. These ‘immune checkpoints’ are important in the protection of healthy, normal tissue from immune-mediated damage (which occurs in auto-immunity, including diseases such as lupus, rheumatoid arthritis, and multiple sclerosis). However, in the context of cancer, immune checkpoints are exploited by cancer cells to protect themselves from destruction by the immune system.
Knowing that tumors utilize these ‘brakes’ and how they work inside the T-cell and in tumors led to Nobel prize-winning research and the development of a type of immunotherapy called immune checkpoint blockade. You might be familiar with several of the commonly used drugs for immune checkpoint blockade, including ipilimumab (Yervoy), nivolumab (Opdivo), pembrolizumab (Keytruda), cemiplimab (Libtayo), atezolizumab (Tecentriq), avelumab (Bavencio), and durvalumab (Imfinzi). These drugs block the immune checkpoints and release the ‘brakes’ on the immune system, thereby reinvigorating T-cells so they can recognize mutated peptides within the tumor, resist the other suppressive factors within the tumor, and kill the cancer cells.
5
Coming back to our two types of cancers —tumors that have a high number of mutations and are immunologically ‘hot’ and tumors that have a low number of mutations and are immunologically ‘cold’ : Immunologically ‘hot’ tumors have an existing T-cell response against the cancer cells that can be unleashed by immune checkpoint blockade treatment. Cutaneous melanoma, for example, harbors a high number of mutations; this immunologically ‘hot’ status explains why immune checkpoint blockade is effective for many patients with cutaneous melanoma.
Uveal melanoma, on the other hand, has a low mutational burden, meaning that there are not many mutated peptides for T-cells to recognize and react against, and as a consequence, not many T-cells are present within the tumor Uveal melanoma is therefore referred to as immunologically ‘cold’ , and it does not respond well to immune checkpoint blockade because there are not enough pre-existing T-cells to attack the cancer, even once the ‘brakes’ have been released. Furthermore, there are not enough mutated peptides on the cancer cells for the few T-cells that are present to recognize the cancer and initiate its destruction.
Outcomes for uveal melanoma patients have not improved in decades, but the tide may be shifting with the FDA approval of tebe, a new type of bispecific T-cell engager.

T-cell engagers prompt T-cells to kill cancer cells by bringing them close to each other
So how do T-cell engagers cause cancer cells to die? As described above, T-cells are part of our adaptive immune system and can directly kill cancer cells when they recognize those cells based on their mutated peptides that are presented by the MHC molecule on the malignant cells. This process is effective when mutational burden is high and there are a lot of mutated peptides to recognize, as with cutaneous melanoma. However, in tumors where mutational burden is low, T-cells simply do not recognize cancer cells as a threat because their lack of mutated peptides makes them appear like healthy cells.
Enter bispecific T-cell engagers. T-cell engagers are large molecules with two parts, one of which specifically binds to cancer cells, while the other specifically binds to and stimulates T-cells. T-cell engagers are given intravenously and then circulate in the bloodstream until they encounter a tumor cell displaying the antigen recognized by the Tcell engager. Once associated with the tumor cell, the T-cell binding portion of the engager can bind to any T-cell that is in the vicinity. This binding event keeps the T-cell in close proximity to the cancer cell and activates its biochemical machinery to undergo the steps required to kill the malignant cells.

On a molecular level, all this is possible because the two “binding” parts of the T-cell engager each bind to only a certain type of protein. The ‘cancer-specific’ part of the T-cell engager binds to proteins that are only present on tumor cells. We call these cancerspecific proteins tumor-associated antigens (TAAs). The ‘T-cell specific’ part of the T-cell engager binds to a protein that is expressed on all T-cells called CD3 (see Fig. 1).
After patients are given the T-cellengagers they circulate through the bloodstream until they come across cancer cells, and their cancer-binding part (blue inpicture) binds to the TAA on the cancer cell surface. After binding to the cancer cell, the T-cell binding part of the T-cell engagerbinds to CD3 on bypassing T-cells and keeps them close to the cancer cell while activating the T-cell. The active T-cell then killsthe cancer cell. (Created with BioRender com)
Importantly, T-cell engagers are able to overcome one of the challenges associated with immunologically ‘cold’ tumors. As noted above, these types of tumors do not contain a pre-existing cancer-specific immune response—meaning they don’t have a mass of dysfunctional cancer-specific T-cells present—that can be reinvigorated by immune checkpoint inhibitors. T-cell engagers circumvent this problem by prompting non-tumor specific T-cells to attack the cancer cells. This process means that T-cells can be redirected against cancer cells by the bispecific engager, regardless of whether the T-cell would otherwise have recognized a mutated cancer cell peptide, since the T-cell engager recognizes the TAA presented by the cancer cell and activates the T-cell through binding to CD3. Once T-cells have been activated and induced to kill cancer cells, they secrete molecules that recruit other T-cells, which causes more and more immune cells to infiltrate the tumor—another way that T-cell engagers solve the issues associated with ‘cold’ tumors.
To review so far: T-cells are immune cells that can kill cancer cells if the T-cells recognize mutated peptides on the cancer cell surface that differentiate the cancer cell from a healthy cell. But cancers that are immunologically ‘cold’ have few mutations and therefore a low number of mutated peptides for T-cells to recognize. Further, these cancers often have only few T-cells present inside the tumor, resulting in a low ratio of T-cells to tumor cells and poor T-cell killing of tumor. Bispecific T-cell engagers are drugs designed to solve these issues by redirecting T-cells to tumor antigens and by stimulating T-cells to kill tumor cells. The engager puts these two cells close together, activating the T-cells so that T-cells can kill the cancer cells. You can see how the name bispecific T-cell engager is an apt description of the drug, as it ‘specifically’ binds to two (‘bi’) cell types and ‘engages’ Tcells to kill cancer cells.
This leads to a lot of cancer-reactive Tcells to enter the tumor and kill the tumor cells by recognizing its mutated peptides. This type of cancer is what we call immunologically ‘hot’
Figure 1 Schematic depiction of how T-cell engagers prompt T-cells to kill cancer cells
6
A new type of T-cell engager enters the clinic
The bispecific T-cell engagers described above—including blinatumomab, an engager directing T-cells to the CD19 protein on B cell leukemia cells—are engineered to recognize the malignant cells through an antibody-based structure, and they work because antibodies can specifically recognize and bind to proteins (the TAAs) on the surface of cancer cells.
Unfortunately, in cancer immunotherapy only 10% of all proteins are present on the surface of a cell and available for antibody-based T-cell engagers to recognize and bind to. That means that 90% of proteins—and therefore 90% of the markers that differentiate between cancer and healthy cells—will be present only on the inside of a cancer cell. A lot of cancers, then, would not respond to a bispecific T-cell engager, because the engager wouldn’t be able to identify a TAA on the surface of the cancer cell to distinguish it from healthy cells. But what if we could target the 90% of proteins inside of the cell as possible TAAs, so that T-cell engagers could identify the cancer cell and bind with it?
Here is where the innovation around tebe comes into play. Unlike the first T-cell engagers that employ two antibodies, tebe and other T-cell engagers currently under development use a T-cell receptor structure instead of antibody to recognize a peptide displayed by the MHC on the tumor cell surface. The other side, which is the part of the T-cell engager that binds to CD3 on T-cells, is an antibody that stimulates CD3, which is important for Tcell activation. Using T-cell receptors as part of a T-cell engager, therefore, allows the engager to bind to TAAs that wouldn’t be accessible to antibody-based T-cell engagers like blinatumomab. This difference is critical for treating cancers where there are no or only few TAAs found on the surface of the cell—such as uveal melanoma. Once T-cells are activated by a T-cell engager and start destroying cancer cells, signals are released, alerting nearby T-cells that cancerous cells are present, resulting in a cascade of T-cell-mediated cancer cell destruction.
The cancer-binding part of tebe targets a peptide derived from the TAA called gp100, a protein that is only present on the inside of melanocytes and melanoma cells. One caveat that comes with the use of T-cell receptor-based bispecific T-cell engagers is that the MHC molecule (which is required to recognize peptides on the surface of cancer cells) comes in many different forms that we inherit from our parents. A specific T-cell receptor can only recognize peptides displayed on selected MHC proteins. Tebe is targeted against gp100 presented by HLA-A*02:01, which is the most common MHC variant but is still present in only about half of all humans. In order to receive tebe for advanced uveal melanoma, patients will need to be tested for the presence of HLAA*02:01, which is required for the drug to be active. Ongoing research is likely to develop other forms of bispecific engager that depend on different MHC types.
A first success in uveal melanoma
FDA approval of tebe was based on the results of a phase 3 clinical trial in which the drug showed statistically and clinically meaningful overall survival benefit for patients with unresectable or metastatic uveal melanoma (read the published article here) Uveal melanoma is an aggressive form of melanoma affecting the eye and eventually spreading to other parts of the body, almost always the liver, in about half of the patients. This tumor is very aggressive and has only rarely responded to any other form of therapy, making it an unmet clinical need with patients currently surviving on average only one year after metastasis is diagnosed. While this drug was the first to be approved for uveal melanoma, there are multiple other treatments for uveal melanoma still in clinical trials. These treatments include antibody-drug conjugates, combination therapies, cancer vaccines, and adoptive T-cell therapies. It remains to be seen how well these approaches fare in trials.
There are also a number of other T-cell receptor-based bispecific T-cell engagers currently under development, as other companies also believe in the potential of targeting tumor-specific peptides that are derived from proteins within cancer cells.

This includes Immatics’ IMA401 and IMA402, which are being tested in a number of solid tumors such as non-small cell lung cancer and melanoma, and AbbVie’s ABBV-189 which is also being tested in vaThis includes Immatics’ IMA401 and IMA402, which are being tested in a number of solid tumors such as non-small cell lung cancer and melanoma, and AbbVie’s ABBV-189 which is also being tested in various cancers Despite this promising first approval of a T-cell receptor based bispecific T-cell engager, obstacles remain. As with other immunotherapies, tumors sometimes develop alternative mechanisms to resist the immune response or to escape from the immune response and grow back even after initial regression Research is underway to develop better T-cell engagers and combinations with other therapies to increase the benefit of this novel immunotherapy and overcome resistance and escape from potent immunotherapy
Paul Bunk is a Ph.D. Candidate at Cold Spring Harbor Laboratory, a New Yorkbased research institute world-renowned in the fields of cancer biology, neuroscience, and plant biology. Paul works in the group of Semir Beyaz and focuses his research on the impact of metabolism on immune cells and their ability to fight cancer. With this research, the Beyaz Lab sits at the cutting edge of cancer immunology and hopes to help make better immunotherapies for the future.

7
Paul Bunk, Ph.D. Candidate Cold Springs Laboratory
WHAT MAKES AIM’S INTERNATIONAL MELANOMA TISSUE BANK CONSORTIUM
even more valuable
AIM at Melanoma’s major research project, the International Melanoma Tissue Bank Consortium (IMTBC), is the first collaborative fresh frozen primary melanoma tissue bank in the world The most important element of the tissue bank is not surprisingly the tissue itself As you might have read in previous articles, primary melanoma tumor tissue is not regularly banked, and it is even more rarely banked fresh frozen

But what makes IMTBC even more valuable is all the information and samples that accompany each fresh frozen primary tumor tissue, such as the patient’s blood samples and medical record (all privacy protected) One piece of this accompanying information is an Epidemiological Survey we call it the Epi Survey for short The Epi Survey has about 40 questions that ask such things as the patient’s skin color; eye color; indoor tanning experience; outdoor sunburn experience; and family history of cancer. Each piece of tumor tissue, therefore, is accompanied by this treasure trove of corresponding data.
Surveys are a commonly used tool in healthcare epidemiology and antimicrobial stewardship research Surveys allow selection of a relatively large sample of people from a predetermined population, followed by collection of data from those individuals, and may be exploratory, descriptive, or explanatory

The key considerations for research using surveys are that as with other methods, developing and refining a central research question are important, followed by careful consideration of the population being sought
source: ncbi.nlm.nih.gov
8
Once a critical mass of tissues and data are collected from a diverse patient population, the researchers can look at these fresh frozen primary melanomas and the data to find medical signs or indicators of outcomes, called biomarkers. For example, a researcher can look at all the primaries that ended up metastasizing vs. those that did not spread. Are the tissues that metastasized genetically different? Do they have different biomarkers? Another example: A researcher can look at all the primaries that ended up metastasizing and for which treatment was unsuccessful the patient died and compare those primaries to the primaries of patients who responded to treatment. How are those melanomas different? Do they have different biomarkers? And so on
The Epi Survey adds a new dimension to this process, as the information in it goes beyond that which is in the typical medical record The Epi Survey will allow researchers to ask and answer questions that may yield important insights for all of us
We know, for example, that those with blue and green eyes are at higher risk for melanoma. But what will we find when we compare primary tissue samples from people who have blue and green eye color with tissue samples from people with other eye colors? Does lighter eye color have any impact on metastases in other words, do more people with lighter eye color see their disease advance? Or is there no correlation between eye color and disease advancement?

Another query could be related to those who have used indoor tanning devices and have developed melanoma Are there differences in the primary tumors of those who have used indoor tanning devices and those who have not? Is there any difference in disease advancement between the two groups?

9
The Epi Survey asks specific questions about the patient’s own cancer history as well as the patient’s family cancer history, which may yield information we ’ ve never considered For example, a researcher can look at tissue from those who have no known cancers in their immediate blood relatives and compare it with tissue from those who have melanoma in their immediate blood relatives
Are the primaries different are there different biomarkers? Researchers will also be able to question how cancers may be connected. Are the primary tumors different for those who have no known cancers in their immediate blood relatives and those who have, for example, breast cancer or pancreatic cancer?
Another question could be asked about patients who have two melanoma primaries: What differences can be found in these primaries if any?
Researchers can also work in the reverse direction. As they look at a large number of primary tumor tissues, they may find specific genetic features in those, and different, but also specific genetic features in those that metastasized (spread) Then they will look to see if they can tie any of those genetic features back to something that is found in the Epi Survey. In other words, researchers will be able to look at the molecular causes of cancer or of metastases in these tissues and may be able to correlate those findings back to features on patients’ skin or in their histories, which may give us a new risk factor to make people aware of The benefit, in this case, would be a new angle for clinical prevention and awareness
The possible questions are endless because of the sheer amount of data that accompanies these primary tumor tissues
You may have heard the saying Tissue is the Issue And it is: As noted earlier, researchers cannot easily find fresh frozen primary melanoma tissue But data is also the issue And together tissue and data they are a goldmine for researchers.


"But data is also the issue. And together tissue and data they are a goldmine for researchers."
10
"A biobank of fresh frozen primary melanoma tissues is truly the pot of gold for research. Critical information is available in the primary tumor—information we cannot get in metastasized tumors, such as predictive and prognostic factors. And when primary tumors are fresh frozen, RNA is intact, and the cell’s immune response is visible. This bank will be a treasure trove for researchers."
 M.D., Ph.D., Chair, Department of Dermatology and Director, Melanoma Research Program, Oregon Health & Science University Knight Cancer Institute, and principal investigator for the tissue bank site at OHSU
Sancy
M.D., Ph.D., Chair, Department of Dermatology and Director, Melanoma Research Program, Oregon Health & Science University Knight Cancer Institute, and principal investigator for the tissue bank site at OHSU
Sancy
Leachman,













 WHY IS FRESH FROZEN TISSUE IMPORTANT?
WHY IS FRESH FROZEN TISSUE IMPORTANT?

 By Paul Bunk, Ph.D. candidate, Cold Springs Harbor Laboratory
By Paul Bunk, Ph.D. candidate, Cold Springs Harbor Laboratory

M.D., Ph.D., Chair, Department of Dermatology and Director, Melanoma Research Program, Oregon Health & Science University Knight Cancer Institute, and principal investigator for the tissue bank site at OHSU
Sancy
M.D., Ph.D., Chair, Department of Dermatology and Director, Melanoma Research Program, Oregon Health & Science University Knight Cancer Institute, and principal investigator for the tissue bank site at OHSU
Sancy
